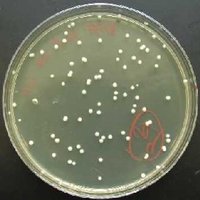
Yeast cells (Saccharomyces cerevisiae)

Back
BackFoundations and Diversity of Microbiology: Key Concepts and Historical Milestones
Study Guide - Smart Notes

Introduction to Microbiology
Scope and Importance of Microbiology
Microbiology is the study of organisms too small to be seen with the naked eye, including bacteria, archaea, fungi, protozoa, algae, and viruses. This field is foundational to understanding disease, ecology, genetics, and biotechnology.
Applications: Microbiology impacts public health, food safety, industry, and environmental science.
Major Groups: Prokaryotes (bacteria, archaea), eukaryotes (fungi, protists), and viruses.
Disproving Spontaneous Generation
Historical Experiments and Key Figures
The theory of spontaneous generation posited that life could arise from non-living matter. This was disproved through a series of experiments by pioneering microbiologists.
Antonie van Leeuwenhoek: First to accurately describe bacteria and other microorganisms, using handcrafted microscopes.
Louis Pasteur: Demonstrated that microorganisms do not arise spontaneously but from other microbes, using swan-neck flask experiments.





Big Names in Microbiology History
Antonie van Leeuwenhoek (1632–1723)
Known as the "Father of Microbiology," Leeuwenhoek was the first to observe and describe microorganisms, which he called "animalcules." His work laid the foundation for the field.
Microscope Innovation: Developed simple microscopes with high-quality lenses.
Discovery: Observed bacteria, protozoa, and other microscopic life forms.
Louis Pasteur (1822–1895)
Pasteur made significant contributions to microbiology, including disproving spontaneous generation, describing fermentation, and developing vaccines for anthrax and rabies.
Pasteurization: Process of heating liquids to kill harmful microbes.
Vaccines: Developed early vaccines for anthrax and rabies.
Robert Koch (1843–1910)
Koch established the germ theory of disease and developed methods for isolating pure cultures of bacteria. He identified the causative agents of anthrax, tuberculosis, and cholera.
Koch's Postulates: Criteria to establish a causative relationship between a microbe and a disease.
Nobel Prize: Awarded in 1905 for his work on tuberculosis.





Koch’s Postulates
Establishing Microbial Causation of Disease
Koch’s postulates are a set of criteria used to link a specific microorganism to a specific disease. They remain foundational in medical microbiology.
The specific causative agent must be found in every case of the disease.
The disease organism must be isolated in pure culture.
Inoculation of a sample of the culture into a healthy, susceptible animal must produce the same disease.
The disease organism must be recovered from the inoculated animal.

Germ Theory of Disease
Microorganisms as Agents of Disease
The germ theory of disease states that specific diseases are caused by specific kinds of microorganisms. This theory replaced earlier ideas of miasma and spontaneous generation, leading to advances in hygiene, vaccination, and antimicrobial therapy.
Impact: Revolutionized medicine and public health, leading to the "Golden Age of Microbiology."
Survey of the Microbial World
Major Domains and Groups
Microorganisms are classified into three domains: Bacteria, Archaea, and Eukarya. Each domain contains diverse groups with unique characteristics.
Bacteria: Prokaryotic, diverse shapes (rod, sphere, spiral), rigid cell walls, reproduce by binary fission, some motile by flagella.
Archaea: Prokaryotic, similar shapes to bacteria, often extremophiles (high salt, temperature, or pH), molecularly more similar to eukaryotes.
Eukarya: Includes fungi, protists (algae, protozoa), plants, and animals. Eukaryotic cells have a nucleus and membrane-bound organelles.
Fungi
Fungi are eukaryotic organisms that obtain energy by decomposing organic material. They can be single-celled (yeasts) or multicellular (molds, mushrooms).
Cell Wall: Made of chitin or cellulose.
Importance: Decomposers, some are pathogens, used in food and biotechnology.

Algae
Algae are photosynthetic eukaryotes found in aquatic environments. They have rigid cell walls made of cellulose and contain chlorophyll.
Role: Primary producers in aquatic ecosystems.


Protozoa
Protozoa are single-celled eukaryotes found in water and soil. They lack cell walls and are usually motile, using flagella, cilia, or pseudopodia.
Pathogenicity: Some protozoa cause diseases in humans.


Bacteria
Bacteria are prokaryotic microorganisms with diverse shapes and metabolic capabilities. They reproduce by binary fission and can be found in nearly every environment.
Cell Wall: Composed of peptidoglycan.
Motility: Many move using flagella.

Archaea
Archaea are prokaryotes that often inhabit extreme environments, such as hot springs, salt lakes, and deep-sea vents. They share some molecular features with eukaryotes.
Extremophiles: Thrive in high temperature, high salt, or acidic environments.



Viruses
Viruses are acellular infectious agents that require a living host to replicate. They can infect all forms of life, including bacteria (bacteriophages), archaea, and eukaryotes.
Structure: Composed of genetic material (DNA or RNA) surrounded by a protein coat; some have lipid envelopes.
Reproduction: Obligate intracellular parasites.

Applications and Impact of Microbiology
Public Health, Industry, and Food Safety
Microbiology is essential for understanding and controlling infectious diseases, ensuring food safety, and advancing biotechnology. The field has contributed to major improvements in life expectancy and quality of life.
Public Health: Vaccination, sanitation, and antimicrobial drugs have reduced infectious disease mortality.
Industry: Microbes are used in fermentation, pharmaceuticals, and waste treatment.
Food Safety: Microbial testing and pasteurization prevent foodborne illnesses.


Domain | Cell Type | Cell Wall Composition | Examples |
|---|---|---|---|
Bacteria | Prokaryotic | Peptidoglycan | Escherichia coli, Staphylococcus aureus |
Archaea | Prokaryotic | Varied (no peptidoglycan) | Halobacterium, Thermoproteus |
Eukarya | Eukaryotic | Cellulose (plants, algae), chitin (fungi), none (animals, protozoa) | Saccharomyces cerevisiae, Volvox, Amoeba |
Additional info: This table summarizes the main differences among the three domains of life relevant to microbiology.
